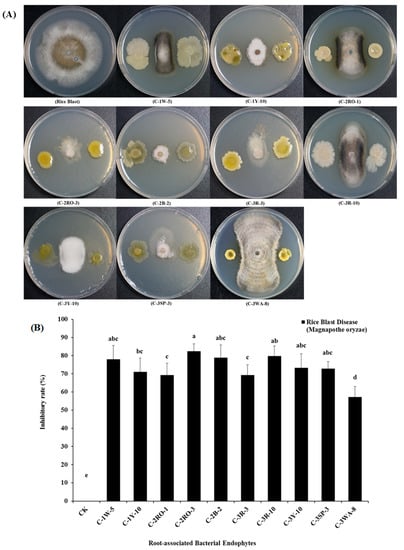
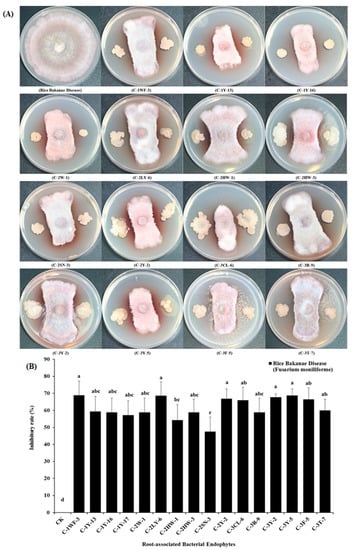

Abstract
Rice (Oryza sativa L.) is a major cereal food crop worldwide, and its growth and yield are affected by several fungal phytopathogens, including Magnaporthe oryzae, Fusarium graminearum, F. moniliforme, and Rhizoctonia solani. In the present study, we have isolated and characterized root-associated bacterial endophytes that have antifungal activities against rice fungal phytopathogens. A total of 122 root-associated bacterial endophytes, belonging to six genera (Bacillus, Fictibacillus, Lysinibacillus, Paenibacillus, Cupriavidus, and Microbacterium) and 22 species were isolated from three rice cultivars. Furthermore, the 16S rRNA sequence-based phylogeny results revealed that Bacillus was the most dominant bacterial genera, and that there were 15 different species among the isolates. Moreover, 71 root-associated endophytes showed antagonistic effects against four major fungal phytopathogens, including M. oryzae, F. graminearum, F. moniliforme, and R. solani. Additionally, the biochemical, physiological, and PCR amplification results of the antibiotic-related genes further supported the endophytes as potential biocontrolling agents against the rice fungal pathogens. Consequently, the findings in this study suggested that the isolated bacterial endophytes might have beneficial roles in rice defense responses, including several bioactive compound syntheses. The outcomes of this study advocate the use of natural endophytes as an alternative strategy towards the rice resistance response.
1. Introduction
Rice (Oryza sativa L.) is considered to be the most widely used staple food among the cereal crops, as it feeds half of the world’s population [1,2]. However, the average rice yield is less than its potential due to many biotic and abiotic factors [3]. Among the biotic factors, rice blast, rice seedling blight, rice bakanae, and rice sheath blight caused by Magnaporthe oryzae, Fusarium graminearum, Fusarium moniliforme, and Rhizoctonia solani, respectively, are the common fungal phytopathogenic diseases causing severe crop damage and losses in yield [4,5,6,7,8]. The annual rice grain yield losses due to major fungal diseases were reported to be rice blast (30%), seedling blight, rice bakanae (50%–60%), and sheath blight (40%–50%) in Asian countries [7,9,10]. At present, the application of fungicides is considered to be the most practiced way of mitigating these fungal diseases of rice. However, the focus has been given to the effective biocontrol of these phytopathogens, as the use of excessive fungicides and chemicals can cause pathogen resurgence and other environmental hazards [11,12]. Several biocontrol approaches have been made to control the respective rice diseases to date [13], of which, the use of root-associated bacterial endophytes has proven to be highly effective. The root-associated bacterial endophytes are responsible for the mechanisms of antagonistic activities against plant fungal phytopathogens by the production of antibiotics, hydrogen cyanide, lytic enzyme activity, catalase, and siderophore [14]. Furthermore, the central role of root-associated endophytes is to prevent phytopathogenic influence and to create competitiveness by producing colonization with the availability of minerals and nutrients [15]. This biocontrol approach is environmentally friendly and effective against biotic and disease stresses. For example, the Pseudomonas chlororaphis EA105 endophytic microbe discovered from rice roots mitigates the disease-causing effect to M. oryzae in vitro and in vivo. The role of P. chlororaphis EA105 has been extensively studied for its possible use as a biological control and the ecological benefits in rice [16,17,18].
The bacterial endophytes (Bacillus pumilus sp., Bacillus subtilis sp., and Pseudomonas fluorescence sp.) have been used to select the microorganisms, through in vitro screening on dual-culture agar plates, where the microbes showed antagonistic abilities against many seed- and soil-borne rice fungal phytopathogens [19,20]. These bacterial species have the characteristics to produce antifungal metabolites and to protect crop plants from fungal infection [21]. Additionally, in modern agriculture, the application of root-associated bacterial endophytes is a prime option, with better antagonistic effects as a biocontrol agent [22]. However, the proper method for the collection of root-associated bacterial endophytes from the various control conditions, as well as its usage as a biocontrol agent against fungal phytopathogens, is largely unknown [23]. Moreover, the molecular screening of antibiotic encoding genes for particular endophytic bacteria, which are responsible for the number of antibiotics and antifungal metabolites production, including cyclic lipopeptides, bio-surfactin, 2, 4-di-acetyl phloroglucinols, pyoluteorin, phenazines, bacillomycins, fengycin, lipopeptides, pyrrolnitrin, celluloses, hydrogen cyanide, polyketide synthase, and non-ribosomal peptide synthases has been considered to be a valuable option for beneficial endophyte selection. These are the most promising bioactive compounds that are associated with biocontrol mechanisms against a wide range of bacterial and fungal phytopathogens [24,25]. The isolation and identification of these endophytic bacteria are essential for agricultural manipulations [26].
Keeping in view the above mentioned important points, the objectives of the present study are to identify and isolate root-associated bacterial endophytes from rice root tissues, by using morphological and molecular approaches to assess the biotic stress problems, and to check their disease suppressing abilities with antagonistic activities for a broad spectrum host range.
2. Results
2.1. Isolation and Identification of Root-Associated Bacterial Endophytes
We successfully isolated 122 culture-able root-associated bacterial endophyte strains based on their visual morphological characterizations from the surface-sterilized roots of available rice cultivars in the field, such as Xiushui-48, Y-003, and CO-39. The isolation frequencies of these bacterial endophytes were further demonstrated on the Luria Brentani agar medium (LB). Among these bacterial endophytes, 45 were conformed from the Xiushui-48 cultivar (C-1), 40 endophytes from the Y-003 cultivar (C-2), and 37 endophytes were detected from the CO-39 cultivar (C-3) (Table 1).

Table 1.
The molecular characterizations of root-associated bacterial endophytes isolated from different rice cultivar roots by 16S rRNA gene sequencings.
2.2. Molecular Classification and 16S rRNA Gene Sequences Based Phylogeny Association of Root-Associated Bacterial Endophytes
The initially isolated 122 root-associated bacterial endophytes were confirmed by molecular characterization through the 16S rRNA gene sequences for the identification of bacterial species. Furthermore, these bacterial endophytes were identified at a high threshold level of about ≥99%–100% compared with most associated bacterial type strains. The screened bacterial endophytes sequence data were submitted to the NCBI GenBank, under the following accession numbers: MN543754 to MN543875. Based on the 16S rRNA gene, the results showed that the 122 cultured root-associated bacterial endophytes were highly associated with six genera (Bacillus, Fictibacillus, Lysinibacillus, Paenibacillus, Cupriavidus, and Microbacterium). These genera were sub-divided into the 22 different bacterial species separately, and the Bacillus genera were the most dominant ones within the isolated root-associated bacterial endophyte. Moreover, among the isolates, the most abundant species in the root-associated bacterial endophytes were Bacillus altitudinis ssp. (28 isolates), Bacillus aryabhattai ssp. (16 isolates), Bacillus cereus ssp. (12 isolates), Bacillus fusiformis ssp. (9 isolates), Fictibacillus phosphorivorans ssp. (9 isolates), and Cupriavidus metallidurans ssp. (9 isolates) respectively. Among the remaining isolates, the bacterial endophyte species were found with different numbers of isolates, such as Bacillus marisflavi ssp. (8 isolates), Bacillus wiedmannii ssp. (8 isolates), Fictibacillus nanhaiensis spp. (4 isolates), Bacillus subterraneous spp. (3 isolates), Bacillus thioparans ssp. (2 isolates), Lysinibacillus mangiferihumi ssp. (2 isolates), Paenibacillus cucumis ssp. (2 isolates), and Paenibacillus alvei ssp. (2 isolates) respectively. Whilst other bacterial endophytes i.e., Bacillus pseudomycoides ssp., Bacillus lehensis ssp., Bacillus acidiceler ssp., Bacillus tequilensis ssp., Bacillus indicus ssp., Bacillus toyonensis ssp., Paenibacillus uliginis ssp., and Microbacterium laevaniformans ssp. were found with one strain. Further, these 122 root-associated bacterial endophyte strains, identified by the 16S rRNA gene sequences relationship with the best match type strains (T) from the NCBI database, and the 16S rRNA gene sequences-based phylogeny are presented in Table 1 and Figure 1.

Figure 1.
The 16S rRNA gene sequences-based phylogeny of all the 122 root-associated bacterial endophytes isolated from different rice cultivars. The 16S rRNA gene sequences were clustered to the MUSCLE alignment through the neighbor-joining method and the 16S rRNA gene sequences-based phylogeny was concatenated by inputting the 16S rRNA gene sequences into the MEGA 7 software. The above green, red, blue, yellow, pink, dark red and black, colored circle symbols represent different bacterial species such as; Bacillus ssp., Fictibacillus ssp., Lysinibacillus ssp., Cupriavidus ssp., Paenibacillus ssp., Microbacterium ssp., and reference type strains. The scale bar value indicates to the bootstrap analysis from (1000) replicates for the genetic distance.
2.3. Biochemical and Physiological Characterization of Root-Associated Bacterial Endophytes
The in-vitro screening results were verified and summarized for the 122 root-associated bacterial endophytes, with respect to their biochemical and physiological traits, with positive and negative symbol indications given in Table S2. Among these 122 root-associated bacterial endophytes, 112 bacterial endophytes showed gram-positive reactions (GPR) and 10 isolates showed gram-negative reactions (GNR). The classification on the basis of their role in different activities, i.e., catalase activity (CA), endospore activity (EA), and oxidase activity (OA), where 104, 96, and 102 isolates showed positive reactions, and 18, 26, and 20 bacterial isolates had negative reactions, respectively. Similarly, 71, 72, and 92 isolates showed positive reactions, and 51, 50, and 30 showed negative reactions, regarding motility performance (MP), citrate activity (CA), and gelatinase production (GP), respectively. Moreover, 110 isolates showed a positive response, and 12 isolates showed a negative reaction, to urease activity (UA), 64 isolates showed a positive reaction and 58 isolates showed a negative reaction in nitrate reduction activity (NRA). There were 98 positive and 24 negative reactions related to the Voges–Proskauer performance (VPP). Furthermore, 113 isolates showed a positive reaction and 9 isolates showed a negative reaction for the methyl red activity (MRA). For starch hydrolyze activity (SHA), 94 bacterial endophytes expressed a positive reaction and 28 isolates had a negative reaction. We found 100 isolates with a positive reaction and 22 isolates with a negative reaction for the glucose activity (GA). With concern to the mannitol activity (MA), lactose activity (LA), and maltose activity (MA), 113, 110, and 84 bacterial endophytes were found as positive and 9, 12, and 38 isolates had a negative response, respectively.
2.4. In-vitro Antagonistic Activities of Root-Associated Bacterial Endophytes
The in-vitro dual-culture test has been extensively used for preliminary screening of biocontrol agents against several fungal phytopathogens. In this study, a total of 122 root-associated bacterial endophytes were isolated using the in-vitro antagonistic tests. However, from these bacterial endophytes, the following 10 strains i.e., C-1W-5, C-1Y-10, C-2RO-1, C-2RO-3, C-2B-2, C-3R-3, C-3R-10, C-3Y-10, C-3SP-3, and C-3WA-8 belonged to the Bacillus altitudinis ssp., Fictibacillus phosphorivorans ssp., and Cupriavidus metallidurans ssp. These strains were exhibited very strong antifungal antagonistic potential with varying amounts of mycelial inhibitory rates ranging from 57.2% to 82.4%, under dual-culture assay subjected to the rice blast (Magnaporthe oryzae) pathogen (Figure 2A,B).
Figure 2.
Biocontrol potentials of different root-associated bacterial endophytes to rice blast (Magnaporthe oryzae). (A) The above plates represent in-vitro antifungal inhibitory activities by dual-culture antagonistic tests of different root-associated bacterial endophytes against rice blast (Magnaporthe oryzae) phytopathogen. (B) The above selected graphical bars indicate antifungal inhibition percentages of radial mycelial growth of (Magnaporthe oryzae) by the 10 root-associated bacterial endophytes, respectively. Values are denoted as mean ± SE (n=3). Values followed by different letters are significantly different (p≤0.05) according to the least significant difference (LSD) test.
Similarly, about 20 isolates strains (i.e., C-1CL-2, C-1CL-4, C-1Y-9, C-1Y17, C-2Y-1, C-2Y-2, C-2-Y-6, C-2RO-1, C-2RO-3, C-2LY-2, C-2LY-5, C-2LY-6, C-2HW-1, C-3R-1, C-3R-3, C-3R-8, C-3R-10, C-3Y-2, C-3Y-5, and C-3CL-8) among all bacterial endophytes were validated with high antagonistic activities against the mycelia growth (Fusarium graminearum), a fungal pathogen of rice seedling blight. Their inhibitory growth zones ranged from 58.0% to 72.6% of the respective pathogen under the dual-culture test results. Further, these 20 root-associated bacterial endophytes are closely associated with the B. altitudinis ssp., B. wiedmannii ssp., B. aryabhattai ssp., B. marisflavi ssp., B. indicus ssp., and F. phosphorivorans ssp., respectively (Figure 3A,B).

Figure 3.
Biocontrol potential of different root-associated bacterial endophytes to rice seedling blight (Fusarium graminearum), (A) the above plates represent in-vitro antifungal inhibitory activities by dual-culture antagonistic tests of different root-associated bacterial endophytes against rice seedling blight (Fusarium graminearum) phytopathogen, (B) the above selected graphical bars indicate antifungal inhibition percentages of radial mycelial growth of (Fusarium graminearum), by the 20 root-associated bacterial endophytes respectively. Values are denoted as mean ± SE (n = 3). Values followed by different letters are significantly different (p ≤ 0.05) according to the LSD test.
Moreover, 16 root-associated bacterial endophyte strains (i.e., C-1WF-3, C-1Y-13, C-1Y-16, C-1Y17, C-2W-1, C-2LY-6, C-2HW-3, C-2SN-3, C-2Y-2, C-3CL-6, C-3R-9, C-3Y-2, C-3Y-5, C-3F-5, and C-3T-7) among the total isolates were capable of displaying antagonistically biocontrol activities with the presence of significant inhibitory rates, from 47.5% to 68.9%, against the mycelia (Fusarium moniliforme) growth of rice bakanae. Additionally, the antifungal detected root-associated endophytes belong to various bacterial species, i.e., L. fusiformis ssp., L. mangiferihumi ssp., F. phosphorivorans ssp., B. altitudinis ssp., B. marisflavi ssp., B. cereus ssp., B. aryabhattai ssp., and P. cucumis ssp., respectively (Figure 4A,B).
Figure 4.
Biocontrol potential of different root-associated bacterial endophytes to rice bakanae (Fusarium moniliforme), (A) the above plates represent in-vitro antifungal inhibitory activities by dual-culture antagonistic tests of different root-associated bacterial endophytes against rice bakanae (Fusarium moniliforme), fungal phytopathogen of rice, (B) the above selected graphical bars indicate antifungal inhibition percentages of radial mycelial growth of (Fusarium moniliforme) by the 16 root-associated bacterial endophytes respectively. Values are denoted as mean ± SE (n = 3). Values followed by different letters are significantly different (p ≤ 0.05) according to the LSD test.
Additionally the photographic results explained that the 26 root-associated bacterial endophytes (i.e., C1CL-2, C1CL-4, C1Y-9, C1Y-17, C2RO-1, C2RO-3, C2RO-4, C2LY-2, C2LY-5, C2LY-6, C2Y-1, C2Y-2, C2Y-6, C2B-2, C2W-3, C2S-1, C2D-1, C2HW-1, C3R-1, C3R-3, C3R-8, C3R-10, C3CL-7, C3CL-8, C3Y-5, and C3WA-8) significantly suppressed the mycelial (Rhizoctonia solani) growth of rice sheath blight, with a suitable inhibitory ratio from 37.8% to 64.7%. These results demonstrated the abilities of the biocontrol potential of bacterial isolates having in-vitro dual-culture antagonistic activity. These 26 bacterial endophytes demonstrated that they were affiliated to the following bacterial species: such as B. wiedmannii ssp., B. altitudinis ssp., B. marisflavi ssp., B. aryabhattai ssp., B. indicus ssp., B. tequilensis ssp., B. toyonensis ssp., and F. phosphorivorans ssp., (Figure 5A,B).

Figure 5.
Biocontrol potential of different root-associated bacterial endophytes to rice sheath blight (Rhizoctonia solani), (A) the above plates represent in-vitro antifungal inhibitory activities by dual-culture antagonistic tests of different root-associated bacterial endophytes against rice sheath blight (Rhizoctonia solani), fungal phytopathogen of rice, (B) the above selected graphical bars indicate antifungal inhibition percentages of radial mycelial growth of (Rhizoctonia solani), by the 26 root-associated bacterial endophytes respectively. Values are denoted as mean ± SE (n = 3). Values followed by different letters are significantly different (p ≤ 0.05) according to the LSD test.
After the investigation of the antagonistic activity of isolated root-associated endophytes, we observed that B. altitudinis ssp. and F. phosphorivorans ssp., showed efficient biocontrol abilities against the tested phytopathogens, whereas B. aryabhattai ssp. and B. marisflavi ssp., showed antifungal activities against F. graminearum, F. moniliforme, and R. solani phytopathogen species. Meanwhile, nine bacterial endophytes also expressed potential inhibitory effects against the fungal phytopathogens, such as B. wiedmannii ssp., B. indicus ssp., B. tequilensis ssp., B. toyonensis ssp., B. cereus ssp., L. fusiformis ssp., L. mangiferihumi ssp., P. cucumis ssp., and C. metallidurans ssp., respectively. However, the above-mentioned root-associated bacterial endophytes have not been reported previously as biocontrol agents against the four major fungal phytopathogens, i.e., M. oryzae, F. graminearum, F. moniliforme, and R. solani of rice.
2.5. Molecular Detection of Antibiotic Related Genes Based on PCR Amplification of Root-Associated Bacterial Endophytes
We achieved the molecular identification of 12 different antibiotic responsive genes, including 2, 4-DAPG, PLT, PRN, PKSI, NRPS, HCN, Sfp, SrfC, ItuD, FenD, BamC, and Cellulase), through the polymerase chain reaction (PCR) amplification from root-associated bacterial endophyte isolates, and the results are shown in Table S3. The (PCR) based amplification revealed that 91 bacterial endophytes were showed positive bands for 2, 4-DAPG gene, and 110 bacterial endophytes were indicated for the positive expression of the PLT antibiotic gene. Furthermore, positive expression of the PRN gene was also verified from 85 bacterial isolates, and 90 bacterial isolates had a positive amplification of the PKSI gene. Along with these, a total of 102 endophytes expressed positive bands of the NRPS gene, and the HCN gene fragment was also successfully spotted in all 98 bacterial endophytes. The positive detection of the Sfp gene was also observed in 97 bacterial isolates. While, in 111 isolates, SrfC gene bands were positively expressed. In further results from the antibiotic gene amplification, the ItuD gene was positively detected in the 104 bacterial isolates, and FenD positive gene expression was observed in the presence of 104 bacterial endophytes. Similarly, BamC antibiotic gene-positive bands were identified in 111 of the bacterial endophytes, and Cellulase gene bands were observed in 94 bacterial endophytes which were amplified on the bases of the PCR detection (Table S3).
3. Discussion
The current demand for agricultural production requires greater attention to achieve better crop protection from the disease-causing phytopathogens. Many efforts have been made toward sustainable agricultural crop protection using environmentally-friendly biological agents [27]. The symbiotic usages of biological agents such as ‘bacterial endophytes’ within plants can promote plant growth and control diseases. The bacterial endophytes have disease controlling abilities, and have been proven to have cost-effective potential [28]. However, among the bacterial endophytes, the role of root-associated bacterial endophytes in biocontrol is rare. The role of root-associated endophytes in the biocontrol of plant phytopathogens’ diseases with the isolation of the bioactive compound, has proved to be very important [29]. The present study was done to isolate and characterize the root-associated bacterial endophytes and their biocontrol (antagonistic) effects against different fungal phytopathogens under in-vitro conditions. Similar results were reported for root-associated bacterial communities, based on their antagonistic mechanisms [30,31].
In our current investigations, about 122 root-associated bacterial endophytes were isolated from the rice plant. These endophytes were affiliated with six different bacterial genera, including Bacillus, Fictibacillus, Lysinibacillus, Cupriavidus, Paenibacillus, and Microbacterium. The analysis revealed that a Bacillus genus was found as a major root-associated bacterial endophyte. Furthermore, we confirmed that the 16S rRNA gene sequences-based phylogeny has been disclosed and that the above-mentioned genera have been sub-divided into 22 various types of bacterial species which represents the novelty against rice fungal pathogens (Table 1). Similar findings have previously reported 169 endophytic actinobacteria isolates from the various tissues of the host plant, and have identified some rare bacterial genera, such as Amycolatopsis, Actinomycete, Brevibacterium, Kocuria, Leifsonia, Microbacterium, Micrococcus, Micromonospora, Nocardiopsis, Promicromonospora, Pseudonocardia, Rhodococcus, Saccharopolyspora, and Tsukamurella [32].
Similarly, many other bacterial endophytes that promote the plant growth, yield and, suppress the pathogens, have been previously reported. For example, three phyla, Firmicutes, Actinobacteria, and Proteobacteria, from 17 different plant species have been identified. There have been 106 bacterial genera, including Burkholderia, Bacillus, Brevundimonas, Agrobacterium, Achromobacter, and Acinetobacter with 23 various types of bacterial endophytes species, found in these 17 plant species [33]. Additionally, bacterial genera, including Herbaspirillum, Enterobacter, Cladosporium, Flavobacterium, Clavibacter, Streptomyces, Klebsiella, Stenotrophomonas, Rhodococcus, Staphylococcus, Rhizobium, Methylobactrium, Microbacterium, Microbispora, Paenibacillus, Pseudomonas, and Pantoea have been studied for their specific function in the promotion of plant growth, biomass, yield, and their role as biocontrol agents [34,35,36,37,38]. Moreover, researchers have found 77 endophytic bacteria, isolated from the leaves, stems, and roots of the Solanum nigrum plant; 80 bacterial endophytes, identified from Piper nigrum L. cultivated into two indigenous environments; and 115 bacterial endophytes, from 72 varieties of plant’s leaves with the function to work against the pathogens and promoted the plant growth [39,40,41]. Similarly, in the present study, the Bacillus bacterial endophyte species resulted in a rice host plant with an antagonistic response against fungal phytopathogens, and it (Bacillus) could be suggested as a specific genus for the rice plant.
Furthermore in the current investigation, we studied that several types of biochemical and physiological characteristics, including gram reactions (GR), catalase activity (CA), endospore activity (EA), oxidase activity (OA), motility performance (MP), citrate activity (CA), gelatinase production (GP), urease activity (UA), nitrate reduction activity (NRA), Voges–Proskauer performance (VPP), methyl red activity (MRA), starch hydrolyses activity (SHA), glucose activity (GA), mannitol activity (MA), lactose activity (LA), and maltose activity (MA), from the isolated root-associated bacterial endophytes respectively (Table S2). In this study, the isolates were identified on the basis of various biochemical and physiological characteristics. These findings were supported by Passari et al. [32], who also displayed the various positive occurrences of the catalase activity, gram reaction, endospore activity, motility performance, and oxidase activities, from different endophytic actinobacteria isolates, having the same role as a biocontrol.
Similarly, in the present research, we also confirmed certain other biochemical and physiological parameters from bacterial endophytes, such as citrate activity, urease activity, nitrate reduction activity, Voges–Proskauer performance, methyl red activity, and starch hydrolyses activity, glucose activity, mannitol activity, the lactose activity, and maltose activity respectively (Table S2). These results were confirmed by a few studies in past years [24,42], both researchers demonstrated the comparative results of the many biochemical and physiological activities in the positive and negative conditions such as gelatinase production, nitrate reduction, Voges–Proskauer performance, citrate activity, and starch hydrolyses activity, etc., from various bacterial endophytes with similar kind of modes of action against plant pathogens in different crops, respectively [43]. In this regard, our study relates to the root-associated bacterial endophytes in-vitro conditions to investigate the dual-culture response against rice fungal pathogens, with promising roles as biocontrol agents for sustainable agriculture and a friendly ecosystem. Further, various analyses have been defined regarding in-vitro dual-culture antagonistic tests for the screening of many bacillus endophytic bacteria as biocontrol agents against different soil and seed-born fungal pathogens such as S. sclerotiorum, F. oxysporum, R. solani, and P. capsici [5,44,45].
In this study, we discovered 10 root-associated bacterial endophytes against the rice blast disease (Magnaporthe oryzae) pathogen. Among the isolates, 10 (C1W-5, C1Y-10 C2RO-1, C2RO-3, C2B-2, C3R-3, C3R-10, C3Y-10, C3SP-3, and C3WA-8) bacterial endophytes had a positively antagonistic mycelial growth suppression against the phytopathogenic fungi of M. oryzae, with an appropriate inhibitory rate (%) under an in-vitro dual-culture environment. Also these root-associated endophytes were recognized as B. altitudinis ssp., F. phosphorivorans ssp., and C. metallidurans ssp., in the current study. The results are supported by Naureen et al. [46], who identified endophytic bacteria in the rhizosphere of various cereals, i.e., rice, wheat, and maize crops. These isolates were associated with the innovative genera, including Pseudomonas, Bacillus, and Enterobacter as growth promoters and as biocontrol agents under control environments.
Additionally, the results of this experiment are also supported by the results from [16], where the authors tested 11 rhizosphere bacteria against the rice blast fungal pathogen, for the development of biocontrol activities under in-vitro condition. Among these 11 rhizosphere-associated isolates, only Pseudomonas ssp. EA105 exhibited the 90% antagonistic effects against appressoria. Similarly, many studies also supported our results by observing the 60 bacterial isolates from the rice rhizosphere by dual-culture assay, and these isolates showed biocontrol abilities against rice blast (M. oryzae) pathogen [47,48,49]. Furthermore, the in-vitro antagonistic activity of various Streptomyces spp. isolates were also tested against the rice blast pathogen through a dual-culture test, which showed the appropriate microbial screening ability for the biocontrol activities [50].
A further 20 root-associated bacterial endophytes were antagonistically conformed against the rice seedling blight (F. graminearum), a fungal pathogen of rice (Figure 3A,B). These 20 root-associated bacterial endophytes are recognized as biocontrol agents against the antifungal activities of F. graminearum. These root-associated endophytes expressed potential abilities and suppressed mycelial growth with the highest inhibitory rate (%) in the in-vitro dual-culture antagonistic application. The response of the root-associated endophytes against the plant phytopathogens could be due to involvement in their biological mechanisms by control of the extracellular and intracellular enzymatic ribosomal compounds, such as cell divider enzymes, lipases, siderophore, hydrogen cyanide, and proteases, etc.
Moreover, in the recent past researchers have also studied similar aspects about the effective reduction of F. graminearum by the number of bacterial strains such as Bacillus ssp., Streptomyces ssp., and Pseudomonas ssp. [51,52]. Along with the above-mentioned studies, some other antifungal endophytes, such as Cryptococcus spp. and Clonostachys ssp., were reported as biocontrol agents for the head blight of wheat [53,54]. These endophytes, as biocontrol agents, have various kinds of antifungal compounds, which have an effective role against the specific pathogenic fungal growth. For example, the strain CHAO belongs to Pseudomonas fluorescens, which produced the siderophores enzyme, 2, 4-diacetylphloroglucinol, and phenazine compounds, and showed the biocontrol performance against the Gaeumannomyces graminis and Thielaviopsis basicola fungal pathogens [55,56,57]. Further, some strains of Bacillus spp. were detected to have major inhibitory compounds, such as Fengycin and iturin, and represented the solid effects against the F. graminearum rice pathogen [55,56,57]. In addition to these, certain bacterial endophyte strains of B. amyloliquefaciens showed abilities to control F. graminearum formations in wheat crop [58], and some bacterial strains of the P. fluorescent EM-85 with two Bacillus strains MR-11 and MRF from the rhizosphere of maize, showed biocontrol potential against the F. graminearum, M. phaseolina, and F. moniliforme plant–fungal phytopathogens and promoted the plant growth [59].
Further, in this study, 16 root-associated bacterial endophytes were successfully screened out through expressing their biocontrol potentials against the mycelia growth of bakanae “Fusarium moniliforme”, a fungal phytopathogen of rice (Figure 4A,B). These 16 root-associated bacterial endophytes displayed satisfactory biocontrol capacity with a considerable range of inhibitory rate (%) against mycelial (F. moniliforme) growth under dual-culture antifungal antagonistic activities against. These results suggested that the root-associated endophytes showed a highly dominant response on the growth of rice pathogens, and have biocontrol potential against the F. moniliforme, as these endophytes have natural abilities to produce extracellular enzymatic activities, lipases formation, siderophore performances, and proteases activities. However, only a few researchers have studied the biocontrol mechanism through the bacterial endophytes for a rice seedling fungal pathogen [60,61]. Moreover, the findings of our study are supported by Chung et al. [7], who isolated a novel endophytic bacteria B. oryzicola YC7007 strain from the rice roots, with a strong biocontrol inhibition activity against the rice bakanae disease [7]. Along with these, some other Bacillus ssp. and Pseudomonas ssp. bacterial species are well known, with biocontrol activities in contrast to the F. moniliforme for the production of different antibiotics [62]. The biocontrol activities of the bacterial endophytes, including P. cepacia, P. fluorescens, and B. subtilis, have been previously identified against phytopathogenic fungi (F. moniliforme, Pythium, Aphanomyces, R. solani, M. phaseolina, S. rolfsii, and F. oxysporum), i.e., root rot of field pea [63].
The sheath blight (R. solani) is a major and common fungal phytopathogen of the rice plant. In this study, we have identified 26 suppressive root-associated bacterial endophytes (Figure 5A,B). These root-associated bacterial endophytes were confirmed for the detection of antifungal activities to R. solani with the dual-culture antagonistic test. The potential role as biocontrol agents of the 26 root-related bacterial endophytes was studied for the first time against the rice sheath blight disease (Figure 5A,B). Similarly, about 576 bacterial endophytes from the different rice cultivars showed high antagonistic effects against R. solani and F. oxysporum growth under in-vitro conditions and they improve the rice plant growth. Most of these isolates were belong to bacterial genera such as Paenibacillus spp., Microbacterium spp., Bacillus spp., and Klebsiella spp. [64]. Furthermore, Smitha et al. [65] investigated the antifungal effect by the bacterial strain of B. amyloliquefaciens-SN13 against R. solani under in-vitro conditions. Another researcher also investigated that the Bacillus subtilis 330-2 strain, which expressed antagonistically biocontrol activities with a good mycelial inhibition against the different fungal phytopathogens, i.e., R solani AG1, N. oryzae, C. heterostrophus, F. oxysporum B. cinerea, and A. alternate, under in-vitro conditions [66]. Additionally, in the various previously reported bacterial endophytes, isolates from different crops have been applied antagonistically for the biocontrol aspects, and these endophytes showed very solid inhibitory antifungal activities against the different kind of fungal phytopathogens, including some endophytes that displayed antifungal activities against R. solani under in-vitro environments [67,68].
The molecular identification of antibiotic-related genes (2, 4-DAPG, PLT, PRN, PKSI, NRPS, HCN, Sfp, SrfC, ItuD, FenD, BamC, and Cellulase) in the isolated bacterial endophytes, which involved in various biocontrol activities, were assessed by PCR-based amplification (Table S3). In the present study, after the amplification, we found that the majority of root-associated bacterial endophytes clearly displayed a positive indication regarding the 12 antibiotic-related genes. The findings of this study were supported by Kushwaha et al. [24]. They described the PCR based amplification of antibiotic peptide related genes, including ItuD, BmyC, and srfA, from the 19 Bacillus endophytic bacterial strains with their biocontrol character in pearl millet cereal crop [24]. Moreover, Xu et al. (2019) also published similar results related to functional biosynthesis antibiotic-related genes, such as PKSI, NRPS, ItuD, SrfC, and Sfp, by PCR from 33 different endophytic bacterial species, where 26 isolates from Bacillus ssp., showed antifungal activities against different phytopathogens of the mulberry plant respectively [25]. Additionally, the PKSI, PKSII, and NRPS, genes involved in the production of a secondary metabolite against the fungal and bacterial phytopathogens, have been identified in 81 different endophytic actinobacterial species, that were isolated from the Rhynchotoechum ellipticum plant [32]. Further, many positive biocontrol encoding gene traits, such as Pyrrolnitrin, Pyoluteorin, 2, 4-diacetylphloroglucinol, Bacillomycin D, Hydrogen cyanide, Fengycin, Cellulase, and Lytic enzyme from 16 the rhizobacterial isolates, were discovered using several gene-specific primers, which were strongly associated to Bacillus and Pseudomonas bacterial species respectively [14].
The main findings of this study revealed that Bacillus bacterial endophyte species were found in rice host plants with an antagonistic response against fungal phytopathogens, and that Bacillus could be suggested as a specific genus to check the biocontrol response against rice fungal pathogens. Further, this study proposed the effectiveness of PCR based identifications of the antibiotic-related genes, which produce a range of efficient bioactive compounds that are useful to understand the mechanism of antifungal activities of bacterial endophytes against the phytopathogens.
4. Materials and Methods
4.1. Plant Material and Sampling Location
The present research was conducted on the isolation of endophytic bacterial strains from rice roots. Samples for the isolation of the bacterial strain were collected from rice cultivars (Xiushui-48, Y-003, and CO-39) grown in the field. The root samples were collected randomly every 5 meters, from the rice demonstration field of China National Rice Research Institute, (CNRRI), Hangzhou, China. The carefully collected samples were put into sterile polythene bags with proper tagging, kept in darkness to save them from environmental stresses, and then immediately brought to the laboratory in an icebox for surface sterilization.
4.2. Surface Sterilization of Rice Root Tissues
Randomly collected root samples from rice plants were washed with tap water to clean and remove the soil particles. From the separated clean root samples, about 15 g were taken and cut into 2–3 cm fine pieces with a sterile surgical blade. Then these small pieces were put on sterile Petri plates for initial sterilization and later the samples were again rewashed with sterilized double-distilled water (ddH2O) ten times with 2–4 min intervals. These surface-sterilized root samples were immersed in 70% ethanol solution for 4 min, and then these samples were sterilized with sodium hypochlorite solution (2.5% chlorine) for 5 min followed by washing three times with ddH2O. Finally, these root samples were washed ten times with ddH2O for 4–5 min to remove the remaining excessive sodium hypochlorite contents. The final sterilized root samples were crushed by autoclaved pestle and mortar to obtain the extract, under the laminar airflow hood (Suzhou Antai Air Technology Co., Ltd., Suzhou, China). From the extract, the 5µl solution was taken and placed on Luria–Brentani (LB) solid agar medium plates with three replications. The inoculated LB plates were incubated at 30 ± 2 °C in a growth incubator for 24–72 hours for observation of the initial growth of root-associated bacterial colonies [69].
4.3. Isolation of Root-Associated Bacterial Endophytes
After the confirmation of the initial growth observations of root-associated bacterial endophytic colonies, the single bacterial colonies based on morphological characteristics were re-streaked on LB agar plates, and the samples were incubated at 30 ± 2 °C for 24 hours in the dark, for the culture purification of root-associated bacterial endophytic strains. Once the bacterial isolates were purified, the single bacterial colonies from each of the purified plate samples were inoculated separately into separately 12 mL Eppendorf tubes containing 2 mL liquid LB medium. These inoculating bacterial tubes were grown overnight in a shaking incubator, at 28 ± 2 °C with 200 rounds per min (rpm) in dark conditions. After the overnight incubation, 1 ml of each endophytic bacterial strain were transferred into 2 mL pre-sterilized Eppendorf tubes containing an equal quantity (1 mL) of 40% (v/v) glycerol, and all isolated endophytic strains were preserved at −80 °C for further use. Further, 1 mL bacterial colonies were used for the DNA extraction and amplification of 16S rRNA genes [70].
4.4. Biochemical and Physiological Characterization of Root-Associated Bacterial Endophytes
The classification of biochemical properties, including; gram reaction (GR), catalase activity (CA), endospore activity (EA), oxidase activity (OA), motility performance (MP), citrate activity (CA), and gelatinase production (GP) were detected from each of the root-associated bacterial endophytes followed by Kushwaha et al. [24]. Determination of the physiological traits, such as; starch hydrolyses activity (SHA), nitrate reduction activity (NRA), Voges–Proskauer performance (VPP), methyl red activity (MRA), glucose activity (GA), mannitol activity (MA), lactose activity (LA), and maltose activity (MA) of all the bacterial endophytes were characterized by following Islam et al. [42]. All analysis was repeated three times and respective results of all tests are mentioned with positive and negative symbols (Table S2).
4.5. Genomic DNA Extraction of Root-Associated Bacterial Endophytes
The genomic DNA extraction from root-associated bacterial endophytes was performed using the DNAiso Reagent Kit (TaKaRa Biotechnology, Co., Ltd, Dalian, China) according to the manufacturer’s instructions. The quantity and quality of genomic DNA were observed by the Nano Drop 2000c Spectrophotometer (Thermo Fisher Scientific, Waltham, MA, USA) at the 260 nm and 280 nm. The purity of the extracted bacterial genomic DNA samples was further assessed through the 1% agarose gel electrophoresis with a 1 x TAX buffer solution, following the described procedure of Koh et al. [71].
4.6. PCR Amplification and Classification of Root-Associated Bacterial Endophytes
The total extracted DNA from each isolate was used for 16S rRNA gene amplification using the Sanger sequencing method from (Sangon Biotechnology Co., Ltd., Shanghai, China). The PCR amplification was performed by using a 50 µL mixture reaction and the 16S rRNA gene was amplified through two universal bacterial primer sets, 27F (5’-AGAGTTTGATCTTGGCTCAG-3’) and 1492R (5’TACGGTTACCTTGTTACGACTT- 3’). The 50 µL PCR mixture reaction contains 1 µL of DNA template (50 ng genomic DNA), 5.0 µL (10 x PCR reaction buffer), 4.0 µL of dNTPs (2.5 mM) mixture, 0.5 µL rTaq DNA polymerase (Thermo Fisher Scientific, Waltham, USA), 0.75 µL from each of 27F and 1492R primer (20 mM), and the remaining volume adjusted up to 50 µL with autoclaved ultra-pure distilled water (ddH2O) with some modifications [72]. The 16S rRNA amplification was performed in a Bioer xp PCR thermal cycler with the following conditions: the initial denaturation was done at 94 °C for 5 min, followed by 30 amplification cycles, annealing at 55 °C for the 30 s, an extension at 72 °C for 90 s, and the final extension step at 72 °C for 5 min. The amplified DNA products were loaded with 6× DNA loading buffer (Thermo Fisher Scientific, Waltham, USA) in 1% agarose gel (w/v) using in 1x Tris-acetate EDTA (TAE) buffer solution for one hour at 100 V electrophoresis. The agarose gel was stained with GelRed (Biotium Inc.) and the PCR product bands were examined under UV light in a UV transilluminator (Bio-Red Molecular Imager Gel Doc XR+ system). Whereas the DNA band gel image was captured with Image Lab Software. Furthermore, the remaining amplified 16S rRNA gene products were sent to the sequencing to the commercial laboratory (TaKaRa Biotechnology Co., Ltd, Dalian, China) for sequencing. The 16S rRNA gene sequences of the bacterial isolates were assembled and matched by EzBioCloud (www.ezbiocloud.net), and also searched against the National Centre for Biotechnology Information (NCBI) database to identify the corresponding homologous sequences for this using Basic Local Alignment Search Tool (BLAST) (http://www.ncbi.nlm.nih.Gov/BLAST).
4.7. 16S rRNA Gene Sequences Based Phylogeny Analysis of Root-Associated Bacterial Endophytes
The 16S rRNA gene sequences-based phylogeny analysis was performed on the bases of 16S rRNA gene sequences and established that the taxonomic position of the bacterial endophytes was aligned, using the MUSCLE alignment through the neighbor-joining method, by the most closely related bacterial type strains [73]. The 16S rRNA gene sequences-based tree was constructed using MEGA 7 software [74] with the bootstrap values for 1000 replications [75].
4.8. Rice Fungal Phytopathogens and Culture Condition
The four rice fungal phytopathogenic diseases, rice blast (M. oryzae), rice sheath blight (R.solani), rice bakanae disease (F. moniliforme), and seedling blight of rice (F. graminearum), were preserved in the research laboratory. All disease-causing fungal pathogens were obtained from the respective laboratory culture collections, and disease mycelia were initially grown on the potato dextrose agar (PDA) medium with the following composition (potato-200 g/L, D-glucose-20 g/L, and agar-15 g/L), and the medium was autoclaved at the 121 °C for 20 min. The initially important rice pathogens were inoculated on PDA plates and these plates were incubated at 28 °C for 7–10 days for better mycelia development according to the disease growth habit (DGH), and rice pathogens were cultured three to five times, following Bibi et al. [70] with little modification. After the 7–10 days of initial growth incubation, a 5 mm diameter mycelial disc was picked from every fungal pathogenic disease and then the 5 mm disc was again placed on freshly prepared PDA plates. These plates were further incubated at 28 °C for 7–10 days. The dual-culture antagonistic activities of the entire root-associated bacterial strains were determined through measuring the inhibitory zones of mycelial development on the fungal pathogens from the PDA medium plates under in-vitro conditions. Every single clone of root-associated bacterial strains was picked up from the per-culture stoke and was then inoculated in 2 mL liquid LB medium, and the inoculated tubs were placed in shaking incubator overnight at 28 °C and 200 rpm. Further, 3 µL from each overnight amplified bacterial culture was stacked twice on the PDA plates under in-vitro conditions, and 3 µL of culture was inoculated on the fresh prepared PDA medium at two opposite side corners with an equal distance of 3 cm from the center. Finally, the inoculated plates were incubated at 28 ± 1 °C for 24 hours. After the 24-hour incubation, the freshly grown fungal mycelium was applied from fungal plates and 5 mm diameter plug discs were placed at the center of PDA plates. After that, the plates were sealed with the para-film under the dark condition and incubated at 28 °C which is the ideal requirement of the pathogenic diseases’ developments. The inhibitory zone of grown fungal pathogens was determined by recording the diameter of the inhibition area (cm). The rate of inhibition percentage was calculated with the following formula, as reported by Shakeel et al. [76].
4.9. Molecular Detection of Antibiotic Related Genes Based on PCR Amplification of Root-Associated Bacterial Endophytes
The total genomic DNA of all bacterial endophytes was extracted using the DNAiso Reagent Kit (TaKaRa Biotechnology Co., Ltd, Dalian, China), according to the manufacturer’s instructions. The isolated DNA of each endophytes was used to detect the number of genes related to antibiotic biosynthesis, such as 2, 4-diacetyphloroglucinol (2, 4-DAPG), pyoluteorin (PLT), pyrrolnitrin (PRN), polyketide synthase (PKSI), non-ribosomal peptide synthetases (NRPS), hydrogen cyanide (HCN), surfactin biosynthesis (Sfp), surfactin synthase (SrfC), iturin A biosynthesis (ItuD), fengycin biosynthesis (FenD), bacillomycin D (BamC), and cellulase. To investigate the putative antifungal mechanism by the direct antagonism, and the genes associated with the production of antibiotic biosynthesis, substances were determined by using PCR amplification. The specific primers related to antibiotic genes were synthesized according to the selected sequences from the encoding region of all functional genes, as described by [14,25]. The details for the PCR amplification of all functional genes, along with the primers’ information, are presented in Table S1. The PCR amplifications were performed in a 25 µL reaction mixture, and the reaction contains 2 µL (50 ng) of DNA template, 2.5 µL of 10 x PCR reaction buffer (Mg2+ plus), 2 µL (2.5 mM) of dNTPs, 0.5 µL of rTaq DNA polymerase, 1 µL of each (20 mM) primers, as well as (ddH2O) to reach up to 25 µL. The reactions were individually operated by automatic Bio-Rad Thermal Cycler (T100™) respectively.
4.10. Statistical Analysis
All rice root-endophytes were tested against the rice fungal pathogens. The rate of inhibition zone was performed with three biological replications. The whole experiment data were statistically analyzed by one-way analysis of variance (ANOVA) using the statistics software—8.1 version (Analytical Software, Tallahassee, FL, USA). The mean-variance comparison was analyzed by using a Fisher protected least significant difference (LSD) test at the 0.05 probability level. The values were expressed as means ± SE of the successfully inhibited endophytic isolates to phytopathogens.
5. Conclusions
We concluded that 122 root-associated bacterial endophytes in rice plant were obtained with a diversity of physiological and biochemical characteristics against fungal phytopathogens. According to the 16S rRNA gene sequencings and its phylogeny analysis, the results showed that B. altitudinis ssp. and B. aryabhattai ssp. were found as the predominant endophytes. Additionally, 71 root-associated bacterial endophytes successfully presented antagonistic activities against the M. oryzae, F. graminearum, F. moniliforme, and R. solani fungal phytopathogens of rice. Furthermore, we confirmed that most of the bacterial endophytes exhibited positive growth in biochemical and physiological properties, and that the majority of bacterial endophytes indicated a strong ability with different biocontrol traits, which is responsible for the antifungal activities through biosynthesis of encoding antibiotic responsive genes. The current experimental findings were highly encouraging for the theory that most of the root-associated bacterial endophytes have significant biocontrol potential against the major fungal phytopathogens with antagonistic effects. These bacterial endophytes could be considered beneficial for dual purposes, including plant growth-promoting activities, development of biopesticides, and biofertilizers for sustainable agriculture and environment safety. Moreover, the outcomes of this research identify new bacterial groups as biocontrol agents with a better capacity to defend the rice from fungal pathogenic diseases for sustainable agriculture and environmental safety.
Supplementary Materials
The following are available online at https://www.mdpi.com/2076-0817/9/3/172/s1, Table S1: List of used primers in the present study for detection of biosynthesis antibiotic-related genes, from potential root-associated bacterial endophytes, by PCR amplifications, Table S2: Identifications of biochemical and physiological characteristics of root-associated bacterial endophytes derived from rice host, Table S3: Molecularly determination of functional biosynthesis antibiotic-related genes from root-associated bacterial endophytes.
Author Contributions
Imagined and planned the research experiment, M.A.K., L.W., G.C., L.C., and G.F.; data recording and performed the experimentation, M.A.K., D.S., L.C., and S.L.; exploration and proper data analysis, M.A.K. and L.W.; authentication, M.A.K., L.W., G.C., and G.F.; manuscript writing—review and editing, M.A.K., L.W., G.C., S.H., and G.F. All authors have read and agree to the published version of the manuscript.
Funding
This research was financially supported by the Innovation Project of the Chinese Academy of Agricultural Sciences, China; the Central Level Public Interest Research Institute for Basic Research and Development Special Fund Business, China (No. 2017RG002-7).
Acknowledgments
This research was conducted in the State Key Laboratory of Rice Biology and Rice Bio-pesticide, China National Rice Research Institute (CNRRI), China. Every author is appreciatively thankful for the research awarding association ship of the Chinese Academy of Agricultural Sciences, (CAAS) and China National Rice Research Institute (CNRRI), which have granted and facilitated us for the completion of this research work by morally as well as financially.
Conflicts of Interest
Every author declared that they have not any conflict of interest regarding this investigation.
Abbreviations
| PCR | = | Polymer Chain Reaction |
| C-1 | = | Cultivar One (Xiushui-48) |
| C-2 | = | Cultivar Two (Y-003) |
| C-3 | = | Cultivar Three (CO-39) |
| CNRRI | = | China National Rice Research Institute |
| LB | = | Luria Bertani |
| PDA | = | Potato Dextrose Agar |
| RPM | = | Rounds Per Mint |
| DGH | = | Disease Growth Habit |
| TAE | = | Tris-acetate EDTA |
| GR | = | Gram Reaction |
| CA | = | Catalase Activity |
| EA | = | Endospore Activity |
| OA | = | Oxidase Activity |
| MP | = | Motility Performance |
| CA | = | Citrate Activity |
| GP | = | Gelatinase Production |
| SHA | = | Starch Hydrolyses Activity |
| NRA | = | Nitrate Reduction Activity |
| VPP | = | Voges Proskauer’s Performance |
| MRA | = | Methyl Red Activity |
| GA | = | Glucose Activity |
| MA | = | Mannitol Activity |
| LA | = | Lactose Activity |
| MA | = | Maltose Activity |
| PLT | = | Pyoluteorin |
| PRN | = | Pyrrolnitrin |
| PKSI | = | Polyketide Synthase |
| NRPS | = | Non-ribosomal Peptide Synthetases |
| HCN | = | Hydrogen Cyanide |
| Sfp | = | Surfactin Biosynthesis |
| SrfC | = | Surfactin Synthase |
| ItuD | = | Iturin A Biosynthesis |
| FenD | = | Fengycin Biosynthesis |
| BamC | = | Bacillomycin D |
| 2,4-DAPG | = | 2, 4-diacetyphloroglucinol |
References
- Slaton, N.A.; Cartwright, R.D.; Meng, J.; Gbur, E.E.; Norman, R.J. Sheath blight severity and rice yield as affected by nitrogen fertilizer rate, application method, and fungicide. Agron. J. 2003, 95, 1489–1496. [Google Scholar] [CrossRef]
- Ben Hassen, M.; Monaco, F.; Facchi, A.; Romani, M.; Valè, G.; Sali, G. Economic Performance of Traditional and Modern Rice Varieties under Different Water Management Systems. Sustainability 2017, 9, 347. [Google Scholar] [CrossRef]
- Rejeb, K.B.; Abdelly, C.; Savouré, A. How reactive oxygen species and proline face stress together. Plant Physiol. Biochem. 2014, 80, 278–284. [Google Scholar] [CrossRef]
- Sang, M.K.; Kim, K.D. Biocontrol activity and primed systemic resistance by compost water extracts against anthracnoses of pepper and cucumber. Phytopathology 2011, 101, 732–740. [Google Scholar] [CrossRef]
- Sadeghi, A.; Hessan, A.; Askari, H.; Aghighi, S.; Shahidi Bonjar, G. Biological control potential of two Streptomyces isolates on Rhizoctonia solani, the causal agent of damping-off of sugar beet. Pak. J. Biol. Sci. 2006, 9, 904–910. [Google Scholar]
- Kim, S.-Y.; Park, D.-S.; Lee, I.-J.; Park, Y.-G.; Seo, J.-H.; Bae, H.-K.; Hwang, C.-D.; Ko, J.-M. Disease incidence, growth, and physiological characterization of rice cultivars with different susceptibility to bakanae disease. Phili. J. Crop. Sci. PJCS 2018, 43, 38–46. [Google Scholar]
- Chung, E.J.; Hossain, M.T.; Khan, A.; Kim, K.H.; Jeon, C.O.; Chung, Y.R. Bacillus oryzicola sp. nov., an endophytic bacterium isolated from the roots of rice with antimicrobial, plant growth promoting, and systemic resistance inducing activities in rice. Plant. Pathol. J. 2015, 31, 152. [Google Scholar] [CrossRef]
- Goswami, R.S.; Kistler, H.C. Heading for disaster: Fusarium graminearum on cereal crops. Mol. Plant Pathol. 2004, 5, 515–525. [Google Scholar] [CrossRef]
- Park, J.W.; Choi, S.-Y.; Hwang, H.-J.; Kim, Y.-B. Fungal mycoflora and mycotoxins in Korean polished rice destined for humans. Int. J. Food Microbiol. 2005, 103, 305–314. [Google Scholar] [CrossRef]
- Mew, T.W.; Cottyn, B.; Pamplona, R.; Barrios, H.; Xiangmin, L.; Zhiyi, C.; Fan, L.; Nil-panit, N.; Arunyanart, P.; Van Kim, P.; et al. Applying Rice Seed-Associated Antagonistic Bacteria to Manage Rice Sheath Blight in Developing Countries. Plant Dis. 2004, 88, 557–564. [Google Scholar] [CrossRef]
- Wang, J.-H.; Ndoye, M.; Zhang, J.-B.; Li, H.-P.; Liao, Y.-C. Population structure and genetic diversity of the Fusarium graminearum species complex. Toxins 2011, 3, 1020–1037. [Google Scholar] [CrossRef]
- Mosquera, G.; Giraldo, M.C.; Khang, C.H.; Coughlan, S.; Valent, B. Interaction transcriptome analysis identifies Magnaporthe oryzae BAS1-4 as biotrophy-associated secreted proteins in rice blast disease. Plant Cell. 2009, 21, 1273–1290. [Google Scholar] [CrossRef]
- Mokiou, S.; Magan, N. Physiological manipulation and formulation of the biocontrol yeast Pichia anomala for control of Penicillium verrucosum and ochratoxin a contamination of moist grain. Biocontrol. Sci. Technol. 2008, 18, 1063–1073. [Google Scholar] [CrossRef]
- Chenniappan, C.; Narayanasamy, M.; Daniel, G.; Ramaraj, G.; Ponnusamy, P.; Sekar, J.; Ramalingam, P.V. Biocontrol efficiency of native plant growth promoting rhizobacteria against rhizome rot disease of turmeric. Biol. Control. 2019, 129, 55–64. [Google Scholar] [CrossRef]
- Elshafie, H.S.; Camele, I.; Racioppi, R.; Scrano, L.; Lacobellis, N.S.; Bufo, S.A. In vitro antifungal activity of Burkholderia gladioli pv. Agaricicola against some phytopathogenic fungi. Int. J. Mol. Sci. 2012, 13, 16291–16302. [Google Scholar] [CrossRef]
- Spence, C.; Alff, E.; Johnson, C.; Ramos, C.; Donofrio, N.; Sundaresan, V.; Bais, H. Natural rice rhizospheric microbes suppress rice blast infections. BMC Plant Biol. 2014, 14, 130. [Google Scholar] [CrossRef]
- Spence, C.A.; Raman, V.; Donofrio, N.M.; Bais, H.P. Global gene expression in rice blast pathogen Magnaporthe oryzae treated with a natural rice soil isolate. Planta 2014, 239, 171–185. [Google Scholar] [CrossRef]
- Spence, C.A.; Lakshmanan, V.; Donofrio, N.; Bais, H.P. Crucial roles of abscisic acid biogenesis in virulence of rice blast fungus Magnaporthe oryzae. Front. Plant Sci. 2015, 6, 1082. [Google Scholar] [CrossRef]
- Luo, J.; Xie, G.; Li, B.; Luo, Y.; Zhao, L.; Wang, X.; Liu, B.; Li, W. Gram-positive bacteria associated with rice in China and their antagonists against the pathogens of sheath blight and bakanae disease in rice. Rice Sci. 2005, 12, 213–218. [Google Scholar]
- Kazempour, M.N. Biological control of Rhizoctonia solani, the causal agent of rice sheath blight by antagonistics bacteria in greenhouse and field conditions. Plant Pathol. J. 2004, 3, 88–96. [Google Scholar]
- Mehnaz, S.; Mirza, M.S.; Haurat, J.; Bally, R.; Normand, P.; Bano, A.; Malik, K.A. Isolation and 16S rRNA sequence analysis of the beneficial bacteria from the rhizosphere of rice. Can. J. Microbiol. 2001, 47, 110–117. [Google Scholar] [CrossRef][Green Version]
- Engelhard, M.; Hurek, T.; Reinhold-Hurek, B. Preferential occurrence of diazotrophic endophytes, Azoarcus spp., in wild rice species and land races of (Oryza sativa L.) in comparison with modern races. Environ. Microbiol. 2000, 2, 131–141. [Google Scholar] [CrossRef]
- Yasmin, S.; Rahman Bakar, M.A.; Malik, K.A.; Hafeez, F.Y. Isolation, characterization and beneficial effects of rice associated plant growth promoting bacteria from Zanzibar soils. J. Basic Microbiol. 2004, 44, 241–252. [Google Scholar] [CrossRef]
- Kushwaha, P.; Kashyap, P.L.; Srivastava, A.K.; Tiwari, R.K. Plant growth promoting and antifungal activity in endophytic Bacillus strains from pearl millet (Pennisetum glaucum). Braz. J. Microbiol. 2019. [Google Scholar] [CrossRef]
- Xu, W.; Wang, F.; Zhang, M.; Ou, T.; Wang, R.; Strobel, G.; Xiang, Z.; Zhou, Z.; Xie, J. Diversity of cultivable endophytic bacteria in mulberry and their potential for antimicrobial and plant growth-promoting activities. Microbiol. Res. 2019, 229, 126328. [Google Scholar] [CrossRef]
- Thomas, P.; Sekhar, A.C. Live cell imaging reveals extensive intracellular cytoplasmic colonization of banana by normally non-cultivable endophytic bacteria. AoB Plants 2014, 6. [Google Scholar] [CrossRef]
- Warrior, P. Living systems as natural crop-protection agents. Pest Manag. Sci. 2000, 56, 681–687. [Google Scholar] [CrossRef]
- Compant, S.; Duffy, B.; Nowak, J.; Clément, C.; Barka, E.A. Use of plant growth-promoting bacteria for biocontrol of plant diseases: Principles, mechanisms of action, and future prospects. Appl. Environ. Microbiol. 2005, 71, 4951–4959. [Google Scholar] [CrossRef]
- Bloemberg, G.V.; Lugtenberg, B.J. Molecular basis of plant growth promotion and biocontrol by rhizobacteria. Curr. Opin. Plant Biol. 2001, 4, 343–350. [Google Scholar] [CrossRef]
- Adhikari, T.B.; Joseph, C.; Yang, G.; Phillips, D.A.; Nelson, L.M. Evaluation of bacteria isolated from rice for plant growth promotion and biological control of seedling disease of rice. Can. J. Microbiol. 2001, 47, 916–924. [Google Scholar] [CrossRef]
- Berg, G.; Kurze, S.; Buchner, A.; Wellington, E.M.; Smalla, K. Successful strategy for the selection of new strawberry-associated rhizobacteria antagonistic to Verticillium wilt. Can. J. Microbiol. 2000, 46, 1128–1137. [Google Scholar] [CrossRef]
- Passari, A.K.; Mishra, V.K.; Singh, G.; Singh, P.; Kumar, B.; Gupta, V.K.; Sarma, R.K.; Saikia, R.; Singh, B.P. Insights into the functionality of endophytic actinobacteria with a focus on their biosynthetic potential and secondary metabolites production. Sci. Rep. 2017, 7, 11809. [Google Scholar] [CrossRef]
- Rosenblueth, M.; Martínez-Romero, E. Bacterial endophytes and their interactions with hosts. Mol. Plant Microbe Interact. 2006, 19, 827–837. [Google Scholar] [CrossRef]
- Ryan, R.P.; Germaine, K.; Franks, A.; Ryan, D.J.; Dowling, D.N. Bacterial endophytes: Recent developments and applications. FEMS Microbiol. Lett. 2008, 278, 1–9. [Google Scholar] [CrossRef]
- Pageni, B.B.; Lupwayi, N.Z.; Larney, F.J.; Kawchuk, L.M.; Gan, Y. Populations, diversity and identities of bacterial endophytes in potato (Solanum tuberosum L.) cropping systems. Can. J. Plant Sci. 2013, 93, 1125–1142. [Google Scholar] [CrossRef][Green Version]
- Verma, P.; Yadav, A.N.; Kazy, S.K.; Saxena, A.K.; Suman, A. Evaluating the diversity and phylogeny of plant growth promoting bacteria associated with wheat (Triticum aestivum L.) growing in central zone of India. Int. J. Curr. Microbiol. Appl. Sci. 2014, 3, 432–447. [Google Scholar]
- Mercado-Blanco, J. Life of Microbes inside the Plant. In Principles of Plant-Microbe Interactions: Microbes for Sustainable Agriculture; Lugtenberg, B., Ed.; Springer: Cham, Switzerland, 2015; pp. 25–32. [Google Scholar]
- Verma, P.; Yadav, A.N.; Khannam, K.S.; Panjiar, N.; Kumar, S.; Saxena, A.K.; Suman, A. Assessment of genetic diversity and plant growth promoting attributes of psychrotolerant bacteria allied with wheat (Triticum aestivum L.) from the northern hills zone of India. Ann. Microbiol. 2015, 65, 1885–1899. [Google Scholar] [CrossRef]
- Long, H.H.; Schmidt, D.D.; Baldwin, I.T. Native Bacterial Endophytes Promote Host Growth in a Species-Specific Manner; Phytohormones Manipulations Do Not Result in Common Growth Responses. PLoS ONE 2008, 3, e2702. [Google Scholar] [CrossRef]
- Aravind, R.; Kumar, A.; Eapen, S. Pre-plant bacterization: A strategy for delivery of beneficial endophytic bacteria and production of disease-free plantlets of black pepper (Piper nigrum L.). Arch. Phytopathol. Plant Protect. 2012, 45, 1115–1126. [Google Scholar] [CrossRef]
- Bhore, S.J.; Sathisha, G. Screening of endophytic colonizing bacteria for cytokinin-like compounds: Crude cell-free broth of endophytic colonizing bacteria is unsuitable in cucumber cotyledon bioassay. World J. Agric. Sci. 2010, 6, 345–352. [Google Scholar]
- Islam, A.; Kabir, M.S. Molecular Identification and Evaluation of Indigenous Bacterial Isolates for Their Plant Growth Promoting and Biological Control Activities against Fusarium Wilt Pathogen of Tomato. Plant Pathol. J. 2019, 35, 137–148. [Google Scholar] [CrossRef]
- Yasmin, S.; Zaka, A.; Imran, A.; Zahid, M.A.; Yousaf, S.; Rasul, G.; Arif, M.; Mirza, M.S. Plant growth promotion and suppression of bacterial leaf blight in rice by inoculated bacteria. PLoS ONE 2016, 11, e0160688. [Google Scholar] [CrossRef]
- Kim, W.-G.; Weon, H.-Y.; Lee, S.-Y. In vitro antagonistic effects of Bacilli isolates against four soilborne plant pathogenic fungi. Plant Pathol. J. 2008, 24, 52–57. [Google Scholar] [CrossRef][Green Version]
- Patil, H.J.; Srivastava, A.K.; Kumar, S.; Chaudhari, B.L.; Arora, D.K. Selective isolation, evaluation and characterization of antagonistic actinomycetes against Rhizoctonia solani. World J. Microbiol. Biotechnol. 2010, 26, 2163–2170. [Google Scholar] [CrossRef]
- Naureen, Z.; Price, A.H.; Hafeez, F.Y.; Roberts, M.R. Identification of rice blast disease-suppressing bacterial strains from the rhizosphere of rice grown in Pakistan. Crop. Protect. 2009, 28, 1052–1060. [Google Scholar] [CrossRef]
- Cazorla, F.; Romero, D.; Pérez-García, A.; Lugtenberg, B.; Vicente, A.D.; Bloemberg, G. Isolation and characterization of antagonistic Bacillus subtilis strains from the avocado rhizoplane displaying biocontrol activity. J. Appl. Microbiol. 2007, 103, 1950–1959. [Google Scholar] [CrossRef]
- Ghazanfar, M.; Waqas, W.; Sahi, S. Influence of various fungicides on the management of rice blast disease. Mycopath 2009, 7, 29–34. [Google Scholar]
- Miah, G.; Rafii, M.; Ismail, M.; Sahebi, M.; Hashemi, F.; Yusuff, O.; Usman, M. Blast disease intimidation towards rice cultivation: A review of pathogen and strategies to control. J. Anim. Plant Sci. 2017, 27, 1058–1066. [Google Scholar]
- Desai, S.; Reddy, M.S.; Kloepper, J.W. Comprehensive testing of biocontrol agents. Biol. Control Crop. Dis. 2002, 3, 387–420. [Google Scholar]
- Palazzini, J.M.; Yerkovich, N.; Alberione, E.; Chiotta, M.; Chulze, S.N. An integrated dual strategy to control Fusarium graminearum sensu stricto by the biocontrol agent Streptomyces sp. RC 87B under field conditions. Plant Gene 2017, 9, 13–18. [Google Scholar] [CrossRef]
- Wang, L.-Y.; Xie, Y.-S.; Cui, Y.-Y.; Xu, J.; He, W.; Chen, H.-G.; Guo, J.-H. Conjunctively screening of biocontrol agents (BCAs) against fusarium root rot and fusarium head blight caused by Fusarium graminearum. Microbiol. Res. 2015, 177, 34–42. [Google Scholar] [CrossRef]
- Xue, A.G.; Chen, Y.; Voldeng, H.D.; Fedak, G.; Savard, M.E.; Längle, T.; Zhang, J.; Harman, G.E. Concentration and cultivar effects on efficacy of CLO-1 biofungicide in controlling Fusarium head blight of wheat. Biol. Control 2014, 73, 2–7. [Google Scholar] [CrossRef]
- Zhang, S.; Schisler, D.A.; Boehm, M.J.; Slininger, P.J. Utilization of chemical inducers of resistance and Cryptococcus flavescens OH 182.9 to reduce Fusarium head blight under greenhouse conditions. Biol. Control 2007, 42, 308–315. [Google Scholar] [CrossRef]
- Dunlap, C.A.; Bowman, M.J.; Schisler, D.A. Genomic analysis and secondary metabolite production in Bacillus amyloliquefaciens AS 43.3: A biocontrol antagonist of Fusarium head blight. Biol. Control 2013, 64, 166–175. [Google Scholar] [CrossRef]
- Zhao, Y.; Selvaraj, J.N.; Xing, F.; Zhou, L.; Wang, Y.; Song, H.; Tan, X.; Sun, L.; Sangare, L.; Folly, Y.M.E. Antagonistic action of Bacillus subtilis strain SG6 on Fusarium graminearum. PLoS ONE 2014, 9, e92486. [Google Scholar] [CrossRef]
- Haas, D.; Défago, G. Biological control of soil-borne pathogens by fluorescent pseudomonads. Nat. Rev. Microbiol. 2005, 3, 307. [Google Scholar] [CrossRef]
- Shi, C.; Yan, P.; Li, J.; Wu, H.; Li, Q.; Guan, S. Biocontrol of Fusarium graminearum growth and deoxynivalenol production in wheat kernels with bacterial antagonists. Int. J. Env. Res. Public Health 2014, 11, 1094–1105. [Google Scholar] [CrossRef]
- Pal, K.; Tilak, K.; Saxcna, A.; Dey, R.; Singh, C. Suppression of maize root diseases caused by Macrophomina phaseolina, Fusarium moniliforme and Fusarium graminearum by plant growth promoting rhizobacteria. Microbiol. Res. 2001, 156, 209–223. [Google Scholar] [CrossRef]
- Miyake, N.; Chilton, J.; Psatha, M.; Cheng, L.; Andrews, C.; Chan, W.-M.; Law, K.; Crosier, M.; Lindsay, S.; Cheung, M. Human CHN1 mutations hyperactivate α2-chimaerin and cause Duane’s retraction syndrome. Science 2008, 321, 839–843. [Google Scholar] [CrossRef]
- Tateishi, U.; Yamaguchi, U.; Seki, K.; Terauchi, T.; Arai, Y.; Hasegawa, T. Glut-1 expression and enhanced glucose metabolism are associated with tumour grade in bone and soft tissue sarcomas: A prospective evaluation by [18 F] fluorodeoxyglucose positron emission tomography. Eur. J. Nucl. Med. Mol. Imag. 2006, 33, 683. [Google Scholar] [CrossRef]
- Raaijmakers, J.M.; De Bruijn, I.; Nybroe, O.; Ongena, M. Natural functions of lipopeptides from Bacillus and Pseudomonas: More than surfactants and antibiotics. FEMS Microbiol. Rev. 2010, 34, 1037–1062. [Google Scholar] [CrossRef]
- Xi, K.; Stephens, J.; Verma, P. Application of formulated rhizobacteria against root rot of field pea. Plant Pathol. 1996, 45, 1150–1158. [Google Scholar] [CrossRef]
- Ji, S.H.; Gururani, M.A.; Chun, S.-C. Isolation and characterization of plant growth promoting endophytic diazotrophic bacteria from Korean rice cultivars. Microbiol. Res. 2014, 169, 83–98. [Google Scholar] [CrossRef]
- Smitha, M.; Singh, R. Biocontrol of phytopathogenic fungi using mycolytic enzymes produced by rhizospheric bacteria of Cicer arietinum. Indian J. Agric. Biochem. 2014, 27, 215–218. [Google Scholar]
- Ahmad, Z.; Wu, J.; Chen, L.; Dong, W. Isolated Bacillus subtilis strain 330-2 and its antagonistic genes identified by the removing PCR. Sci. Rep. 2017, 7, 1777. [Google Scholar] [CrossRef]
- Bach, E.; dos Santos Seger, G.D.; de Carvalho Fernandes, G.; Lisboa, B.B.; Passaglia, L.M.P. Evaluation of biological control and rhizosphere competence of plant growth promoting bacteria. Appl. Soil Ecol. 2016, 99, 141–149. [Google Scholar] [CrossRef]
- Chen, S.; Zhang, M.; Wang, J.; Lv, D.; Ma, Y.; Zhou, B.; Wang, B. Biocontrol effects of Brevibacillus laterosporus AMCC100017 on potato common scab and its impact on rhizosphere bacterial communities. Biol. Control 2017, 106, 89–98. [Google Scholar] [CrossRef]
- Kumar, P.; Dubey, R.C.; Maheshwari, D.K. Bacillus strains isolated from rhizosphere showed plant growth promoting and antagonistic activity against phytopathogens. Microbiol. Res. 2012, 167, 493–499. [Google Scholar] [CrossRef]
- Bibi, F.; Yasir, M.; Song, G.-C.; Lee, S.-Y.; Chung, Y.-R. Diversity and characterization of endophytic bacteria associated with tidal flat plants and their antagonistic effects on oomycetous plant pathogens. Plant Pathol. J. 2012, 28, 20–31. [Google Scholar] [CrossRef][Green Version]
- Koh, M.C.; Lim, C.H.; Chua, S.B.; Chew, S.T.; Phang, S.T. Random amplified polymorphic DNA (RAPD) fingerprints for identification of red meat animal species. Meat Sci. 1998, 48, 275–285. [Google Scholar] [CrossRef]
- Versalovic, J.; Koeuth, T.; Lupski, R. Distribution of repetitive DNA sequences in eubacteria and application to fingerprinting of bacterial genomes. Nucleic Acids Res. 1991, 19, 6823–6831. [Google Scholar] [CrossRef]
- Kim, O.-S.; Cho, Y.-J.; Lee, K.; Yoon, S.-H.; Kim, M.; Na, H.; Park, S.-C.; Jeon, Y.S.; Lee, J.-H.; Yi, H. Introducing EzTaxon-e: A prokaryotic 16S rRNA gene sequence database with phylotypes that represent uncultured species. Int. J. Syst. Evol. Microbiol. 2012, 62, 716–721. [Google Scholar] [CrossRef]
- Tamura, K.; Peterson, D.; Peterson, N.; Stecher, G.; Nei, M.; Kumar, S. MEGA5: Molecular evolutionary genetics analysis using maximum likelihood, evolutionary distance, and maximum parsimony methods. Mol. Biol. Evol. 2011, 28, 2731–2739. [Google Scholar] [CrossRef] [PubMed]
- Felsenstein, J. Confidence limits on phylogenies: An approach using the bootstrap. Evolution 1985, 39, 783–791. [Google Scholar] [CrossRef]
- Shakeel, M.; Rais, A.; Hassan, M.N.; Hafeez, F.Y. Root associated Bacillus sp. improves growth, yield and zinc translocation for basmati rice (Oryza sativa) varieties. Front. Microbiol. 2015, 6, 1286. [Google Scholar] [CrossRef]
© 2020 by the authors. Licensee MDPI, Basel, Switzerland. This article is an open access article distributed under the terms and conditions of the Creative Commons Attribution (CC BY) license (http://creativecommons.org/licenses/by/4.0/).